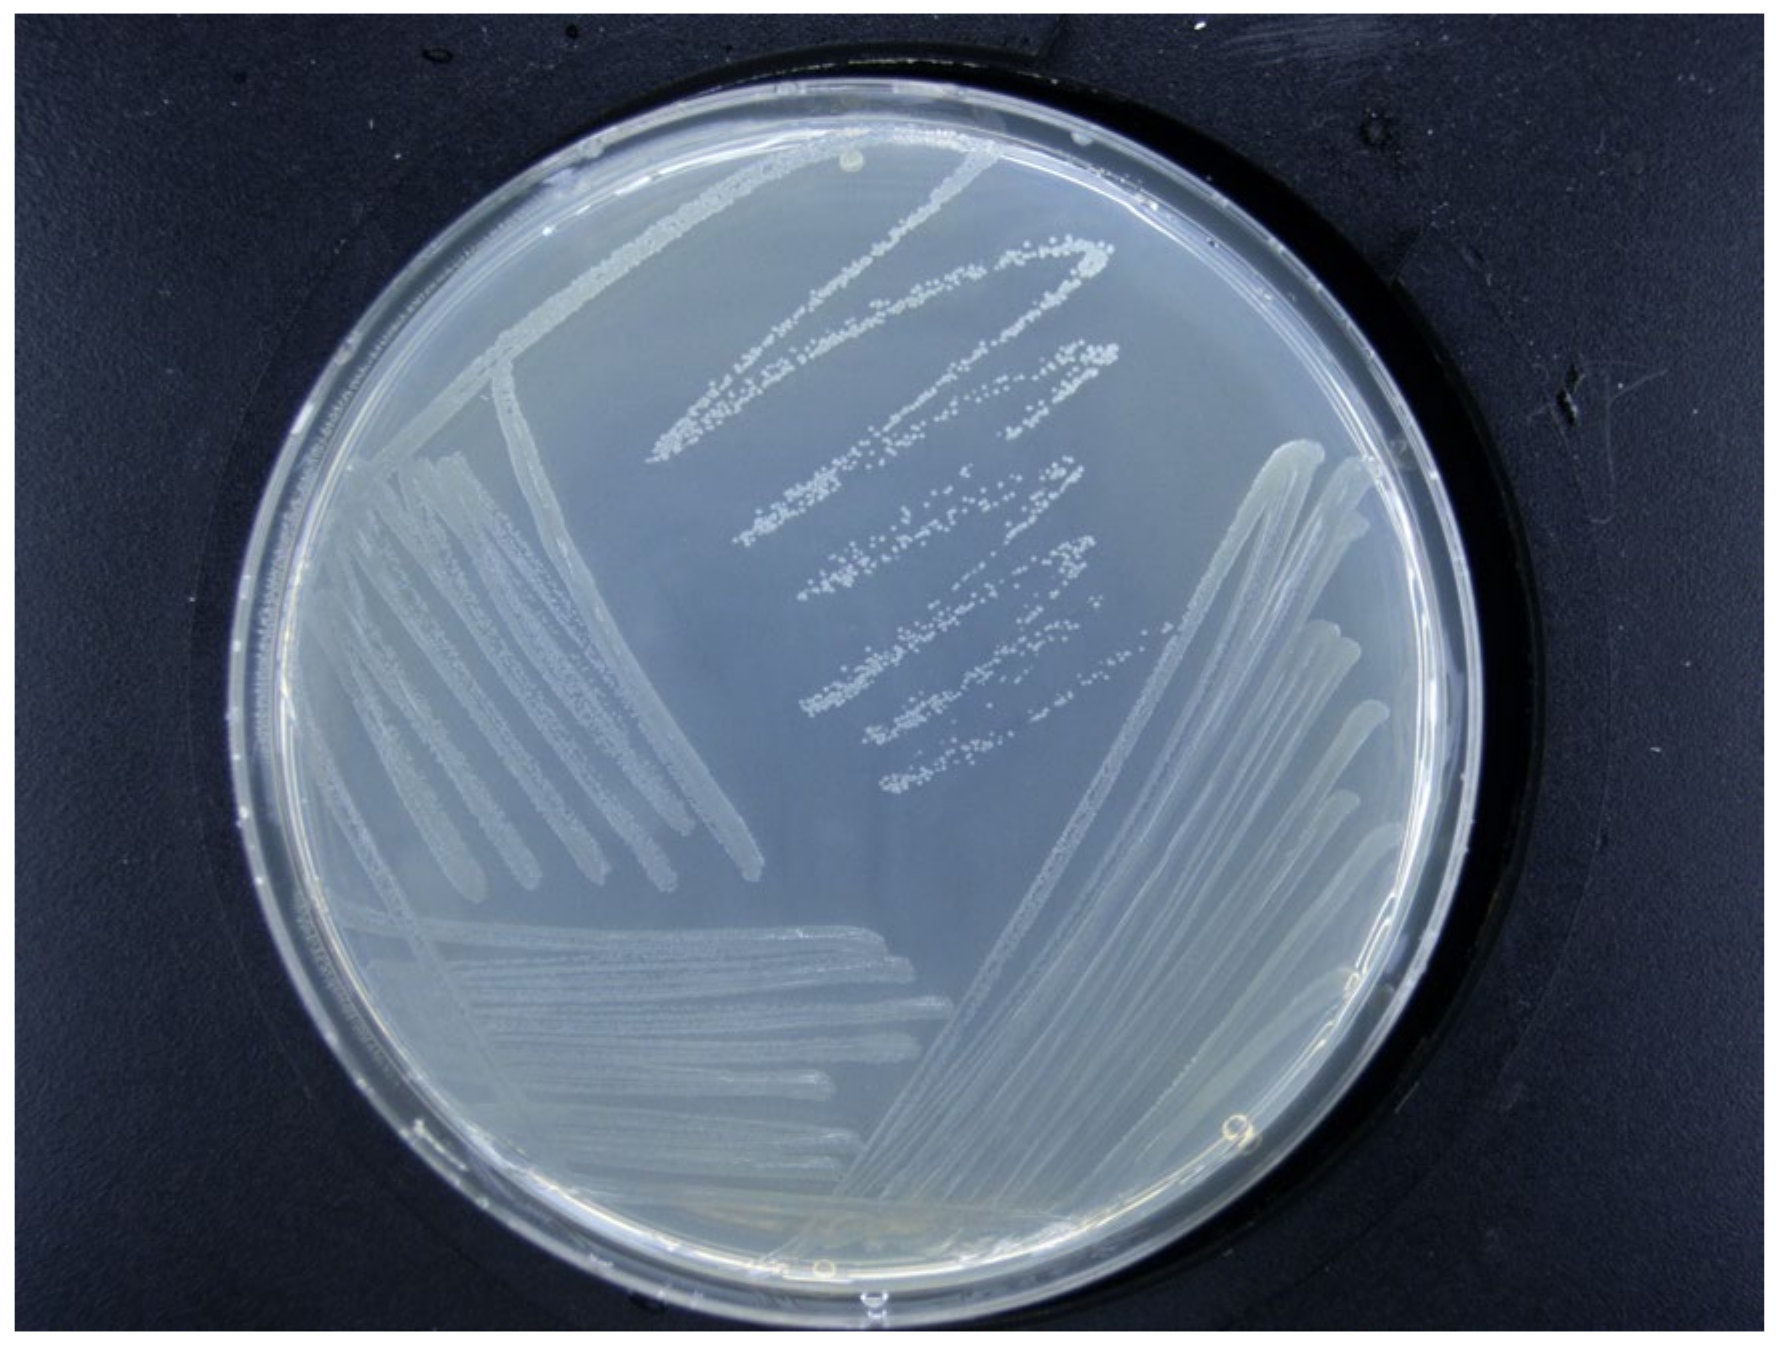
Ijms 26 04438 g003

Evaluation of the Efficacy of Three Antagonistic Bacteria Strains in the Management of Fire Blight
Abstract
1. Introduction
2. Results
2.1. Molecular-Biology-Based Verification Results for Fire Blight Disease
2.2. Morphological Characteristics of Erwinia amylovora
2.3. Pathogenicity of Xea Strains Causing Fire Blight
2.4. The Antibacterial Effects of the Three Antagonistic Bacteria on Agar Plates
2.5. Evaluation of the Indoor Control Efficacy of Three Antagonistic Bacteria Against Fire Blight Disease
2.5.1. Evaluation of the Control Effect of Detached Leaves
2.5.2. Evaluation of the Control Effect of Detached Branches
2.6. Changes in Enzyme Activity and MDA Content in Detached Branches and Leaves After Treatment with Three Types of Antagonistic Bacteria
2.6.1. The Changes of Enzyme Activity and MDA Content of Detached Leaves
2.6.2. The Changes of Enzyme Activity and MDA Content of Detached Branches
2.7. Evaluation of the Outdoor Control Efficacy of Three Antagonistic Bacteria Against Fire Blight Disease
3. Discussion
4. Materials and Methods
4.1. Test Strains
4.2. Experimental Site
4.3. Isolation and Identification of Fire Blight
4.3.1. Isolation and Purification
4.3.2. Molecular Biology Verification
4.3.3. Observation of Morphological Characteristics
4.3.4. Pathogenicity Assessment
4.4. Determination of Antibacterial Activity on Agar Plates
4.5. Indoor Efficacy Determination
4.5.1. Detached Korla Xiangli Leaves
4.5.2. Detached Korla Xiangli Branches
4.6. Determination of Enzyme Activity and MDA Content
4.7. Outdoor Efficacy Evaluation
4.8. Disease Index Statistics
4.9. Data Processing
5. Conclusions
Supplementary Materials
Author Contributions
Funding
Institutional Review Board Statement
Informed Consent Statement
Data Availability Statement
Acknowledgments
Conflicts of Interest
Abbreviations
| Mg-7 | Leuconostoc mesenteroides |
| Rt-10 | Alcaligenes faecalis |
| Rt-11 | Bacillus siamensis |
| POD | peroxidase |
| CAT | catalase |
| SOD | superoxide dismutase |
| PPO | polyphenol oxidase |
| PAL | phenylalanine ammonia-lyase |
| MDA | malondialdehyde |
| EA | Single inoculation with Erwinia amylovora (positive control) |
| CK | Single inoculation with sterile water (negative control) |
| T-7 | Inoculate with the Erwinia amylovora first, followed by Mg-7 |
| T-10 | Inoculate with the Erwinia amylovora first, followed by Rt-10 |
| T-11 | Inoculate with the Erwinia amylovora first, followed by Rt-11 |
| P-7 | Inoculate with Mg-7 first, followed by Erwinia amylovora |
| P-10 | Inoculate with Rt-10 first, followed by Erwinia amylovora |
| P-11 | Inoculate with Rt-11 first, followed by Erwinia amylovora |
| Mg-7-100 | Mg-7 diluted 100-fold |
| Mg-7-200 | Mg-7 diluted 200-fold |
| Mg-7-300 | Mg-7 diluted 300-fold |
| RT-10-100 | RT-10 diluted 100-fold |
| RT-10-200 | RT-10 diluted 200-fold |
| RT-10-300 | RT-10 diluted 300-fold |
| RT-11-100 | RT-11 diluted 100-fold |
| RT-11-200 | RT-11 diluted 200-fold |
| RT-11-300 | RT-11 diluted 300-fold |
Appendix A
| Strain | Sequence |
|---|---|
| Leuconostoc mesenteroides (Mg-7) | GTTGGTTCCTTGCCCTTAAGAACGGCTCCTTCCTAAAAGGTTAGGCCACCGGCTTTGGGCATTACAAACTCCCATGGTGTGACGGGCGGTGTGTACAAGACCCGGGAACGTATTCACCGCGGCGTGCTGATCCGCGATTACTAGCGATTCCGACTTCATGTAGTCGAGTTGCAGACTACAATCCGAACTGAGACGTACTTTAAGAGATTAGCTCACCCTCGCGGGTTGGCAACTCGTTGTATACGCCATTGTAGCACGTGTGTAGCCCAGGTCATAAGGGGCATGATGATCTGACGTCGTCCCCGCCTTCCTCCGGTTTGTCACCGGCAGTCTCGCTAGAGTGCCCATCTGAATGCTGGCAACTAACAATAAGGGTTGCGCTCGTTGCGGGACTTAACCCAACATCTCACGACACGAGCTGACGACGACCATGCACCACCTGTCACTTTGTCTCCGAAGAGAACACTTCTATCTCTAAAAGCTTCAAAGGATGTCAAGACCTGGTAAGGTTCTTCGCGTTGCTTCGAATTAAACCACATGCTCCACCGCTTGTGCGGGTTCCCGTCGTTTTCTTTGAGTTTTTTCTTTTTGGTCGTACTCCCCATGTGGAACACTTTTCGCGTTAGCTTCGGCACTAAGAGGCGGAAACCTCCTAATTTCTATTGTTTCATCTTTTATTGTGTGTACTACTTGGTTTATCTTTTTTTTTGTTACGATATTTATCCTTTCTAGCCTCAACGTCTGTTTGCTGTCCCTGTATCTCCGCCCTTCTCCACTGTCGGTTCTTCCCATATATCTACGCATTCCCCCCGGCTACACATGGGAATTCCACTTTACCCTCCA |
| Alcaligenes faecalis (Rt-10) | TACGGTTAGGCTACCTACTTCTGGTGAAACCCACTCCCATGGTGTGACGGGCGGTGTGTACAAGACCCGGGAACGTATTCACCGCGACATTCTGATCCGCGATTACTAGCGATTCCGACTTCACGCAGTCGAGTTGCAGACTGCGATCCGGACTACGATCGGGTTTCTGAGATTGGCTCCCCCTCGCGGGTTGGCGACCCTCTGTCCCGACCATTGTATGACGTGTGAAGCCCTACCCATAAGGGCCATGAGGACTTGACGTCATCCCCACCTTCCTCCGGTTTGTCACCGGCAGTCTCATTAGAGTGCTCTTGCGTAGCAACTAATGACAAGGGTTGCGCTCGTTGCGGGACTTAACCCAACATCTCACGACACGAGCTGACGACAGCCATGCAGCACCTGTGTTCCGGTTCTCTTGCGAGCACGGCCAAATCTCTTCGGCTTTCCAGACATGTCAAGGGTAGGTAAGGTTTTTCGCGTTGCATCGAATTAATCCACATCATCCACCGCTTGTGCGGGTCCCCGTCAATTCCTTTGAGTTTTAATCTTGCGACCGTACTCCCCAGGCGGTCCACTTCACGCGTTAGCTGCGCTACTAAGGCCTAACGGCCCCAACAGCTAGTTGACATCGTTTAGGGCGTGGACTACCAGGGTATCTAATCCTGTTTGCTCCCCACGCTTTCGTGCCTGAGCGTCAGTATTATCCCAGGGGGCTGCCTTCGCCATCGGTATTCCTCCACATATCTACGCATTTCACTGCTACACGTGGAATTCTACCCCCCTCTGACATACTCTAGCTCGGCAGTTAAAAATGCAGTTCCAAGGTTGAGCCCTGGGATTTCACATCTTTCTTTCCGAACCGCCTACACACGCTTTACGCCCAGTAATTCCGATTAACGCTTGC |
| Bacillus siamensis (Rt-11) | TCCTAGAGGTACCTCACCGACTTCGGGGGTTACAAACTCTCGGGGGGGGACGGGCGGGGTGTACAAGGCCCGGGAACGTATTCACCGCGGCATGCTGATCCGCGATTACTAGCGATTCCAGCTTCACGCAGTCGAGTTGCAAACTGCGATCCGAACTGAAAACAGATTTGTGGGATTGGCTTAACCTCGCGGTTTCGCTGCCCTTTGTTCTGTCCATTGTAGCACGTGTGTAGCCCAGGTCATAAGGGGCATGATGATTTGACGTCATCCCCACCTTCCTCCGGTTTGTCACCGGCAGTCACCTTAAAGTGCCCAACTGAATGCTGGCAACTAAGATCAAGGGTTGCGCTCGTTGCGGGACTTAACCCAACATCTCACGACACGAGCTGACGACAACCATGCACCACCTGTCACTCTGCCCCCGAAGGGGACGTCCTATCTCTAGGATTGTCAGAGGATGTCAAGACCTGGTAAGGTTCTTCGCGTTGCTTCGAATTAAACCACATGCTCCACCGCTTGTGCGGGCCCCCGTCAATTCCTCTTAGTTTCTGTCTTGCGACCGTACTCTCCAGAGCGGAGTGCTCAATGCGTTTTCTGCAGCACTAAGCCCGCGGAAACCCCCTAACACTTATCACTCATCGTTTACGACGTGGACTACCAGGGAATCTAAACTGTTCGGTCCCCGCCGGGTTTTTTTTTTTTTCATTTATTTTTGTCCAGAGAGTCCCCCTCCGCCACTGGTGTTTCCTTCCACATCTCTACGCATTTTCACCGCTACCCGTGGGATTTTCTTCTCTTCCTTCTTCTGCATCTCTATGTTCCCCAGTTTTTCCAATTGAACCTTCCCCCGGGGTTGAGCCGGGGGGGCTTTTCTCACATCAAAACTTAAAGAAAACCCGGCCCTGCCGAGACCCTTTTACCGCCCATTCTAATTTTCTCGGCGCT |
References
- Pedroncelli, A.; Puopolo, G. This tree is on fire: A review on the ecology of Erwinia amylovora, the causal agent of fire blight disease. J. Plant Pathol. 2024, 106, 823–837. [Google Scholar] [CrossRef]
- Bell, R.L. Genetics, genomics, and breeding for fire blight resistance in pear. In The Pear Genome; Springer: Berlin/Heidelberg, Germany, 2019; pp. 243–264. [Google Scholar] [CrossRef]
- Esteban, G.; Álvarez, B.; Santander, R.D.; Biosca, E.G. Screening for novel beneficial environmental bacteria for an antagonism-based Erwinia amylovora biological control. Microorganisms 2023, 11, 1795. [Google Scholar] [CrossRef] [PubMed]
- Chen, J.; Lü, J.; He, Z.; Zhang, F.; Zhang, S.; Zhang, H. Investigations into the production of volatile compounds in Korla fragrant pears (Pyrus sinkiangensis Yu). Food Chem. 2020, 302, 125337. [Google Scholar] [CrossRef] [PubMed]
- Sun, W.; Gong, P.; Zhao, Y.; Ming, L.; Zeng, Q.; Liu, F. Current situation of fire blight in China. Phytopathology 2023, 113, 2143–2151. [Google Scholar] [CrossRef]
- Huang, W.; Sheng, Q.; Luo, M.; Ma, D.; Zhang, C. Occurrence characteristics and Control suggestions of fire blight on Korla Xiangli in Xinjiang. Plant Prot. 2022, 48, 207–213+231. [Google Scholar] [CrossRef]
- Bureau of Statistics of Bayingolin Mongolian Autonomous Prefecture. 2020 Bayingolin Statistical Yearbook. 2021. Available online: http://www.xjbz.gov.cn/xjbz/c111208/jumpxq.shtml (accessed on 15 March 2025).
- Rani, L.; Thapa, K.; Kanojia, N.; Sharma, N.; Singh, S.; Grewal, A.S.; Srivastav, A.L.; Kaushal, J. An extensive review on the consequences of chemical pesticides on human health and environment. J. Clean. Prod. 2021, 283, 124657. [Google Scholar] [CrossRef]
- Chaudhary, R.; Nawaz, A.; Khattak, Z.; Arslan Butt, M.; Fouillaud, M.; Dufossé, L.; Munir, M.; Haq, I.U.; Mukhtar, H. Microbial bio-control agents: A comprehensive analysis on sustainable pest management in agriculture. J. Agric. Food Res. 2024, 18, 101421. [Google Scholar] [CrossRef]
- Zeller, W.; Wolf, B. Studies on biological control of fire blight. Acta Hortic. 1995, 411, 341–346. [Google Scholar] [CrossRef]
- Vanneste, J.; Yu, J. Biological control of fire blight using Erwinia herbicola Eh252 and Pseudomonas fluorescens A506 separately or in combination. Acta Hortic. 1995, 411, 351–354. [Google Scholar] [CrossRef]
- Sharifazizi, M.; Harighi, B.; Sadeghi, A. Evaluation of biological control of Erwinia amylovora, causal agent of fire blight disease of pear by antagonistic bacteria. Biol. Control 2017, 104, 28–34. [Google Scholar] [CrossRef]
- Roselló, G.; Bonaterra, A.; Francés, J.; Montesinos, L.; Badosa, E.; Montesinos, E. Biological control of fire blight of apple and pear with antagonistic Lactobacillus plantarum. Eur. J. Plant Pathol. 2013, 137, 621–633. [Google Scholar] [CrossRef]
- Rajput, V.D.; Harish; Singh, R.K.; Verma, K.K.; Sharma, L.; Quiroz-Figueroa, F.R.; Meena, M.; Gour, V.S.; Minkina, T.; Su-shkova, S.; et al. Recent developments in enzymatic antioxidant defence mechanism in plants with special reference to abiotic stress. Biology 2021, 10, 267. [Google Scholar] [CrossRef] [PubMed]
- Yokoyama, S.; Adachi, Y.; Asakura, S.; Kohyama, E. Characterization of Alcaligenes faecalis strain AD15 indicating biocontrol activity against plant pathogens. J. Gen. Appl. Microbiol. 2013, 59, 89–95. [Google Scholar] [CrossRef]
- Liu, B.; Chen, J.; Luo, Y.; Zhao, Y.; Wang, X.; Cai, Y.; Tang, R.; Shi, Q.; Li, H. Screening of Leuconostoc with antibacterial activity from fermented vegetables and mining of its bacteriocin gene cluster. Food Ind. Technol. 2024, 45, 142–150. [Google Scholar] [CrossRef]
- Zhang, X.; Xu, M.; Yu, J. Biocontrol Effect of Bacillus siamensis ZHX-10 on Peanut Crown Rot. J. Peanut Sci. 2020, 49, 52–56. [Google Scholar] [CrossRef]
- Ab Rahman, S.F.S.; Singh, E.; Pieterse, C.M.J.; Schenk, P.M. Emerging microbial biocontrol strategies for plant pathogen. Plant Sci. 2018, 267, 102–111. [Google Scholar] [CrossRef]
- Oni, F.E.; Kieu Phuong, N.; Höfte, M. Recent advances in Pseudomonas biocontrol. Bact.-Plant Interact. Adv. Res. Future Trends 2015, 167–198. [Google Scholar] [CrossRef]
- Fira, D.; Dimkić, I.; Berić, T.; Lozo, J.; Stanković, S. Biological control of plant pathogens by Bacillus species. J. Biotechnol. 2018, 285, 44–55. [Google Scholar] [CrossRef]
- Veena, V.; Taylor, C.G. Agrobacterium rhizogenes: Recent developments and promising applications. In Vitr. Cell. Dev. Biol.-Plant 2007, 43, 383–403. [Google Scholar] [CrossRef]
- Woo, S.L.; Hermosa, R.; Lorito, M.; Monte, E. Trichoderma: A multipurpose, plant-beneficial microorganism for eco-sustainable agriculture. Nat. Rev. Microbiol. 2023, 21, 312–326. [Google Scholar] [CrossRef]
- Enache-Angoulvant, A.; Hennequin, C. Invasive Saccharomyces infection: A comprehensive review. Clin. Infect. Dis. 2005, 41, 1559–1568. [Google Scholar] [CrossRef] [PubMed]
- Mikiciński, A.; Sobiczewski, P.; Puławska, J.; Malusa, E. Antagonistic potential of Pseudomonas graminis 49M against Erwinia amylovora, the causal agent of fire blight. Arch. Microbiol. 2016, 198, 531–539. [Google Scholar] [CrossRef] [PubMed]
- Nguyen, L.T.T.; Park, A.R.; Van Le, V.; Hwang, I.; Kim, J.C. Exploration of a multifunctional biocontrol agent Streptomyces sp. JCK-8055 for the management of apple fire blight. Appl. Microbiol. Biotechnol. 2024, 108, 49. [Google Scholar] [CrossRef] [PubMed]
- Lu, Y.; Hao, J.; Luo, M.; Huang, W.; Sheng, Q.; Wang, N.; Zhan, F.; Long, X.; Bao, H. Screening of antagonistic bacteria against Erwinia amylovora and its control effect in greenhouse. Microbiol. China 2021, 48, 3690–3699. [Google Scholar] [CrossRef]
- Shemshura, O.; Alimzhanova, M.; Ismailova, E.; Molzhigitova, A.; Daugaliyeva, S.; Sadanov, A. Antagonistic activity and mechanism of a novel Bacillus amyloliquefaciens MB40 strain against fire blight. J. Plant Pathol. 2020, 102, 825–833. [Google Scholar] [CrossRef]
- Cui, Z.; Hu, L.; Zeng, L.; Meng, W.; Guo, D.; Sun, L. Isolation and characterization of Priestia megaterium KD7 for the biological control of fire blight. Front. Microbiol. 2023, 14, 1099664. [Google Scholar] [CrossRef]
- Zhu, X.; Zhao, Y.; Shi, C.; Xu, G.; Wang, N.; Zuo, S.; Ning, Y.; Kang, H.; Liu, W.; Wang, R.; et al. Antagonistic control of rice immunity against distinct pathogens by the two transcription modules via salicylic acid and jasmonic acid pathways. Dev. Cell 2024, 59, 1609–1622. [Google Scholar] [CrossRef]
- Zhao, K.; Li, Y.; Wang, J.; Tu, Y.; Cao, Z.; Ma, X.; Gong, F.; Li, Z.; Zhang, L.; Qiu, D.; et al. Genome-wide characterization of AhBAG genes in peanut reveals their role in bacterial wilt resistance and hormone response. BMC Plant Biol. 2025, 25, 513. [Google Scholar] [CrossRef]
- Ilham, B.; Noureddine, C.; Philippe, G.; Mohammed, E.G.; Brahim, E.; Sophie, A.; Martine, N.; Muriel, M. Induced systemic resistance (ISR) in Arabidopsis thaliana by Bacillus amyloliquefaciens and Trichoderma harzianum used as seed treatment. Agriculture 2019, 9, 166. [Google Scholar] [CrossRef]
- Zehra, A.; Meena, M.; Dubey, M.K.; Aamir, M.; Botanical Studies, R.S.U. Synergistic effects of plant defense elicitors and Trichoderma harzianum on enhanced induction of antioxidant defense system in tomato against Fusarium wilt disease. Bot. Stud. 2017, 58, 44. [Google Scholar] [CrossRef]
- Singh, A.; Kumar, A.; Sharma, P.C.; Kumar, R.; Yadav, R.K. Sodicity stress differently influences physiological traits and anti-oxidant enzymes in pear and peach cultivars. PeerJ 2023, 11, e14947. [Google Scholar] [CrossRef] [PubMed]
- Anderson, J.A. Catalase activity, hydrogen peroxide content and thermotolerance of pepper leaves. Sci. Hortic. 2002, 95, 277–284. [Google Scholar] [CrossRef]
- Gayoso, C.; Pomar, F.; Novo-Uzal, E.; Merino, F.; de Ilárduya, Ó.M. The Ve-mediated resistance response of the tomato to Verticillium dahliae involves H2O2, peroxidase and lignins and drives PAL gene expression. BMC Plant Biol. 2010, 10, 232. [Google Scholar] [CrossRef] [PubMed]
- Li, S.M.; Hua, G.G.; Liu, H.X.; Guo, J.H. Analysis of defence enzymes induced by antagonistic bacterium Bacillus subtilis strain AR12 towards Ralstonia solanacearum in tomato. Ann. Microbiol. 2008, 58, 573–578. [Google Scholar] [CrossRef]
- Chen, F.; Wang, M.; Zheng, Y.; Luo, J.; Yang, X.; Wang, X. Quantitative changes of plant defense enzymes and phytohormone in biocontrol of cucumber Fusarium wilt by Bacillus subtilis B579. World J. Microbiol. Biotechnol. 2010, 26, 675–684. [Google Scholar] [CrossRef]
- Griffiths, B.S.; Philippot, L. Insights into the resistance and resilience of the soil microbial community. FEMS Microbiol. Rev. 2013, 37, 112–129. [Google Scholar] [CrossRef]
- Siddiqui, I.A.; Shaukat, S.S. Mixtures of plant disease suppressive bacteria enhance biological control of multiple tomato pathogens. Biol. Fertil. Soils 2002, 36, 260–268. [Google Scholar] [CrossRef]
- Wang, J.; Niu, Y.; Qin, J.; Han, L.; Chen, W. Field control effect and evaluation of four fungicides against Erwinia amylovora. Agrochemicals 2022, 61, 523–525. [Google Scholar] [CrossRef]
- Tilton, R.C.; Ryan, R.W. Evaluation of an automated agar plate streaker. J. Clin. Microbiol. 1978, 7, 298–304. [Google Scholar] [CrossRef]
- Kim, W.S.; Hildebrand, M.; Jock, S.; Geider, K. Molecular comparison of pathogenic bacteria from pear trees in Japan and the fire blight pathogen Erwinia amylovora. Microbiology 2001, 147, 2951–2959. [Google Scholar] [CrossRef]
- He, L.; Tian, W.; Zhang, X.; Xu, Y.; Ye, C. Research progress on detection and identification technology of fire blight. Mol. Plant Breed. 2023, 21, 7819–7825. [Google Scholar] [CrossRef]
- Li, H.; Zhang, J.; Sheng, Q.; Tang, Z.; Zhang, X.; Zhang, C.; Luo, M. Resistance evaluation of 20 pear varieties (germplasms) in China to foreign strains of Erwinia amylovora. J. Fruit Sci. 2019, 36, 629–637. [Google Scholar] [CrossRef]
- Zheng, P.; Tian, Y.; Wang, J.; Deng, L.; Xiao, D.; Liu, J.; Han, Y.; Li, Z. Isolation and identification of antagonistic bacteria and analysis of antagonistic activity against Staphylococcus aureus. Brew. China 2023, 42, 61–66. [Google Scholar] [CrossRef]
- He, X.; Hang, J.; Sheng, Q.; Luo, M.; Bao, H.; Huang, W. Screening of Antagonistic Bacterium FX1 Against Erwinia amylovora and Its Control Effect of the Antibacterial Substances on Fire Blight. Acta Hortic. Sin. 2023, 50, 1118–1129. [Google Scholar] [CrossRef]
- Usha Rani, P.; Jyothsna, Y. Biochemical and enzymatic changes in rice plants as a mechanism of defense. Acta Physiol. Plant. 2010, 32, 695–701. [Google Scholar] [CrossRef]
- Liu, Y.; Shi, J.; Feng, Y.; Yang, X.; Li, X.; Shen, Q. Tobacco bacterial wilt can be biologically controlled by the application of antagonistic strains in combination with organic fertilizer. Biol. Fertil. Soils 2013, 49, 447–464. [Google Scholar] [CrossRef]
- Campbell, C.L.; Benson, D.M.; Campbell, C.L.; Neher, D.A. Estimating disease severity and incidence. In Epidemiology and Management of Root Diseases; Springer: Berlin/Heidelberg, Germany, 1994; pp. 117–147. [Google Scholar] [CrossRef]

| Different Antagonistic Treatment | Diameter of the Bacteriostatic Circle (mm) |
|---|---|
| Mg-7 | 16.10 ± 0.19 a |
| Rt-10 | 11.04 ± 0.18 b |
| Rt-11 | 9.76 ± 0.12 c |
| 2d | 3d | 4d | 5d | 6d | 7d | 8d | ||
|---|---|---|---|---|---|---|---|---|
| Treatment Group | Disease Index | Disease Index | Disease Index | Disease Index | Disease Index | Disease Index | Disease Index | Control Effect |
| T-7 | 12.21 ± 0.72 b | 14.95 ± 0.95 cd | 18.24 ± 0.73 b | 20.44 ± 0.28 cd | 22.91 ± 0.27 c | 24.28 ± 0.83 d | 24.55 ± 0.82 c | 60.39 ± 0.44 c |
| T-10 | 13.19 ± 0.27 b | 16.59 ± 0.48 b | 19.88 ± 0.28 a | 21.99 ± 0.48 b | 24.55 ± 0.99 b | 27.20 ± 0.48 b | 27.85 ± 0.55 b | 45.95 ± 0.74 e |
| T-11 | 13.07 ± 0.73 ab | 14.95 ± 0.24 c | 19.61 ± 0.27 a | 20.71 ± 0.28 c | 23.28 ± 0.47 bc | 26.02 ± 0.47 c | 26.87 ± 0.48 b | 51.92 ± 0.71 d |
| P-7 | 10.29 ± 0.48 c | 12.75 ± 1.43 de | 16.32 ± 0.27 c | 19.34 ± 0.82 d | 19.61 ± 0.27 e | 22.73 ± 1.99 d | 24.10 ± 0.91 c | 63.30 ± 0.52 b |
| P-10 | 8.91 ± 0.73 d | 11.66 ± 0.95 e | 13.03 ± 0.55 d | 18.29 ± 0.29 e | 19.06 ± 0.55 e | 20.44 ± 1.26 e | 21.81 ± 0.96 d | 76.96 ± 0.46 a |
| P-11 | 10.84 ± 0.48 c | 13.88 ± 0.26 d | 16.60 ± 0.55 c | 18.83 ± 1.98 de | 20.99 ± 0.48 d | 23.81 ± 0.47 d | 25.12 ± 0.95 c | 59.27 ± 0.88 c |
| EA | 14.13 ± 0.54 a | 18.24 ± 0.48 a | 20.44 ± 0.73 a | 23.73 ± 0.99 a | 27.29 ± 0.28 a | 30.31 ± 0.27 a | 32.96 ± 0.27 a | — |
| 2d | 3d | 4d | 5d | 6d | 7d | 8d | ||
|---|---|---|---|---|---|---|---|---|
| Treatment Group | Disease Index | Disease Index | Disease Index | Disease Index | Disease Index | Disease Index | Disease Index | Control Effect |
| T-7 | 5.76 ± 0.41 c | 10.29 ± 0.41 c | 11.52 ± 0.42 c | 13.17 ± 0.44 c | 16.87 ± 0.41 c | 18.93 ± 0.41 c | 19.34 ± 0.31 c | 45.90 ± 0.63 d |
| T-10 | 8.23 ± 0.43 b | 11.93 ± 0.43 b | 13.99 ± 1.09 b | 17.28 ± 0.71 b | 19.34 ± 0.51 b | 20.16 ± 0.43 b | 21.81 ± 0.41 b | 34.64 ± 0.26 f |
| T-11 | 7.82 ± 0.41 b | 11.52 ± 0.42 b | 14.40 ± 0.45 b | 17.69 ± 0.42 b | 18.93 ± 0.41 b | 19.34 ± 0.42 bc | 22.22 ± 0.71 b | 37.23 ± 0.36 e |
| P-7 | 4.94 ± 0.71 cd | 6.47 ± 0.30 d | 10.28 ± 0.82 cd | 11.52 ± 0.41 d | 11.94 ± 0.46 de | 12.76 ± 0.41 e | 16.87 ± 0.41 e | 80.94 ± 0.37 b |
| P-10 | 5.76 ± 0.82 cd | 6.99 ± 0.82 d | 10.29 ± 0.41 d | 12.35 ± 0.71 cd | 12.76 ± 0.41 d | 16.05 ± 0.71 d | 18.11 ± 0.42 d | 55.70 ± 0.62 c |
| P-11 | 4.52 ± 0.42 d | 5.35 ± 0.45 e | 8.08 ± 0.34 e | 10.29 ± 0.82 de | 11.52 ± 0.32 e | 12.35 ± 0.71 e | 12.76 ± 1.09 f | 86.27 ± 0.28 a |
| EA | 10.22 ± 0.45 a | 15.22 ± 0.41 a | 17.69 ± 0.41 a | 19.34 ± 0.41 a | 21.72 ± 0.83 a | 23.87 ± 0.41 a | 26.34 ± 0.52 a | — |
| Day | 15d | 30d | ||
|---|---|---|---|---|
| Treatment Group | Disease Index | Control Effect (%) | Disease Index | Control Effect (%) |
| Mg-7-100 | 7.10 ± 0.81 e | 61.33 ± 3.85 a | 8.64 ± 1.12 f | 63.17 ± 4.72 a |
| Mg-7-200 | 10.80 ± 0.82 d | 39.65 ± 4.56 c | 12.96 ± 0.53 d | 44.84 ± 2.27 b |
| Mg-7-300 | 12.04 ± 0.53 c | 32.76 ± 2.98 d | 15.43 ± 0.31 bc | 34.34 ± 1.32 cd |
| Rt-10-100 | 10.19 ± 0.51 d | 43.09 ± 2.98 c | 12.35 ± 1.11 d | 47.46 ± 4.73 b |
| Rt-10-200 | 12.35 ± 0.82 c | 31.02 ± 4.56 d | 15.12 ± 0.61 bc | 35.64 ± 2.62 c |
| Rt-10-300 | 12.96 ± 1.41 c | 27.60 ± 7.90 de | 16.36 ± 0.81 b | 30.40 ± 3.48 d |
| Rt-11-100 | 8.34 ± 1.43 e | 53.43 ± 3.90 b | 11.11 ± 1.61 de | 52.72 ± 6.83 ab |
| Rt-11-200 | 11.11 ± 1.41 cd | 37.91 ± 7.91 c | 13.24 ± 0.82 d | 36.96 ± 2.27 c |
| Rt-11-300 | 14.2 ± 1.11 b | 20.69 ± 6.21 e | 14.81 ± 0.53 c | 43.68 ± 3.50 b |
| CK | 17.90 ± 0.81 a | — | 23.46 ± 1.72 a | — |
| Treatment Name | Treatment Method |
|---|---|
| Ea | Single inoculation with Erwinia amylovora (positive control) |
| CK | Single inoculation with sterile water (negative control) |
| T-7 | Inoculation with the Erwinia amylovora first, followed by Mg-7 |
| T-10 | Inoculation with the Erwinia amylovora first, followed by Rt-10 |
| T-11 | Inoculation with the Erwinia amylovora first, followed by Rt-11 |
| P-7 | Inoculation with Mg-7 first, followed by Erwinia amylovora |
| P-10 | Inoculation with Rt-10 first, followed by Erwinia amylovora |
| P-11 | Inoculation with Rt-11 first, followed by Erwinia amylovora |
| Treatment Name | Treatment Method |
|---|---|
| CK | Negative control |
| Mg-7-100 | Mg-7 diluted 100-fold |
| Mg-7-200 | Mg-7 diluted 200-fold |
| Mg-7-300 | Mg-7 diluted 300-fold |
| RT-10-100 | RT-10 diluted 100-fold |
| RT-10-200 | RT-10 diluted 200-fold |
| RT-10-300 | RT-10 diluted 300-fold |
| RT-11-100 | RT-11 diluted 100-fold |
| RT-11-200 | RT-11 diluted 200-fold |
| RT-11-300 | RT-11 diluted 300-fold |
Disclaimer/Publisher’s Note: The statements, opinions and data contained in all publications are solely those of the individual author(s) and contributor(s) and not of MDPI and/or the editor(s). MDPI and/or the editor(s) disclaim responsibility for any injury to people or property resulting from any ideas, methods, instructions or products referred to in the content. |
© 2025 by the authors. Licensee MDPI, Basel, Switzerland. This article is an open access article distributed under the terms and conditions of the Creative Commons Attribution (CC BY) license (https://creativecommons.org/licenses/by/4.0/).
Share and Cite
Zhang, J.; Zhang, Z.; Wen, Y.; Zhu, J.; Wufuerjiang, A.; Tian, J. Evaluation of the Efficacy of Three Antagonistic Bacteria Strains in the Management of Fire Blight. Int. J. Mol. Sci. 2025, 26, 4438. https://doi.org/10.3390/ijms26094438
Zhang J, Zhang Z, Wen Y, Zhu J, Wufuerjiang A, Tian J. Evaluation of the Efficacy of Three Antagonistic Bacteria Strains in the Management of Fire Blight. International Journal of Molecular Sciences. 2025; 26(9):4438. https://doi.org/10.3390/ijms26094438
Chicago/Turabian StyleZhang, Jianhui, Zhidong Zhang, Yue Wen, Jing Zhu, Abudusufuer Wufuerjiang, and Jia Tian. 2025. "Evaluation of the Efficacy of Three Antagonistic Bacteria Strains in the Management of Fire Blight" International Journal of Molecular Sciences 26, no. 9: 4438. https://doi.org/10.3390/ijms26094438
APA StyleZhang, J., Zhang, Z., Wen, Y., Zhu, J., Wufuerjiang, A., & Tian, J. (2025). Evaluation of the Efficacy of Three Antagonistic Bacteria Strains in the Management of Fire Blight. International Journal of Molecular Sciences, 26(9), 4438. https://doi.org/10.3390/ijms26094438

